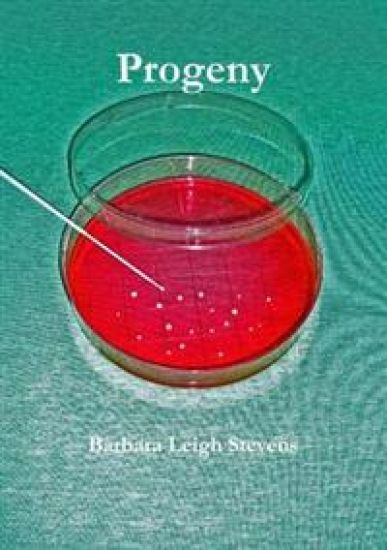
Progeny

Kirjahaku
Etsi kirjoja tekijän nimen, kirjan nimen tai ISBN:n perusteella.
1000 tulosta hakusanalla Steven Leigh Morris



Sports Biomechanics
Boyi Dai; Gerwyn Hughes; Steven Leigh

Costs of Occupational Injuries and Illnesses
J. Paul Leigh; Steven B. Markowitz; Marianne Fahs; Philip J. Landrigan

Pathfinder RPG Treasure Vault Special Edition (P2)
Michael Sayre; Mark Seifter; Kendra Leigh Speedling; Logan Bonner; Dan Cascone; Jessica Catalan; Kim Frandsen; Andrew Geels; Steven Hammond; Sen H.H.S.; Joshua Kim; Dustin Knight

Pathfinder RPG Treasure Vault (P2)
Michael Sayre; Mark Seifter; Kendra Leigh Speedling; Logan Bonner; Dan Cascone; Jessica Catalan; Kim Frandsen; Andrew Geels; Steven Hammond; Sen H.H.S.; Joshua Kim; Dustin Knight

Pathfinder RPG Treasure Vault Pocket Edition (P2)
Michael Sayre; Mark Seifter; Kendra Leigh Speedling; Logan Bonner; Dan Cascone; Jessica Catalan; Kim Frandsen; Andrew Geels; Steven Hammond; Sen H.H.S.; Joshua Kim; Dustin Knight

Pathfinder RPG: Treasure Vault (Remastered) (P2)
Michael Sayre; Mark Seifter; Kendra Leigh Speedling; Logan Bonner; Dan Cascone; Jessica Catalan; Kim Frandsen; Andrew D. Geels; Sen H.H.S.; Steven Hammond; Michelle Y. Kim; Dustin Knight

Pathfinder RPG: Treasure Vault (Remastered) Special Edition (P2)
Michael Sayre; Mark Seifter; Kendra Leigh Speedling; Logan Bonner; Dan Cascone; Jessica Catalan; Kim Frandsen; Andrew D. Geels; Sen H.H.S.; Steven Hammond; Michelle Y. Kim; Dustin Knight

Pathfinder RPG: Treasure Vault (Remastered) Pocket Edition (P2)
Michael Sayre; Mark Seifter; Kendra Leigh Speedling; Logan Bonner; Dan Cascone; Jessica Catalan; Kim Frandsen; Andrew D. Geels; Sen H.H.S.; Steven Hammond; Joshua Kim; Dustin Knight

Simulation i sundhedsvæsenet
Susanne Piilgaard Hallin; Anne Lippert; Doris Østergaard; Kenneth Lübcke; Jette Led Sørensen; Barbara Hoff Esbjørn; Martin Grønnebæk Tolsgaard; Hanne Selberg; Charlotte Paltved; Ebbe Thinggaard; Peter Dieckmann; Anne-Mette Helsø; Lotte Abildgren; Mikkel Lønborg Friis; Kristian Krogh; Trine Grundtvig Jensen; Farsana Khan; Eva Ørsted Sery; Kenneth Boe Krarup; Marlene Mohr; Allan Sørensen; Steven Arild Wuyts Andersen; Lucy Leigh Bray; Rune Dall Jensen; Anna Sofie Mundt; Søren Mikkelsen

In His Hands: My Seven-Year Detour Through Cancer
Monica Leigh Nelson

The Seven Deadly Sins of Sales: and the Deceptively Simple Strategies to Solve Them
Leigh Brown

Nee^rland's glorie. De geschiedenis der Nederlandsche Republiek van 1648-1713 ... Met illustratie¨n van J. C. Leich.
Steven Ten Cate; J C Leich

Dawn of the Stars, The Story of the Seven Sisters
Nathan W. C. Leigh; Aaron M. Geller; Taeho Ryu

Dawn of the Stars, The Story of the Seven Sisters
Nathan W. C. Leigh; Aaron M. Geller; Taeho Ryu
